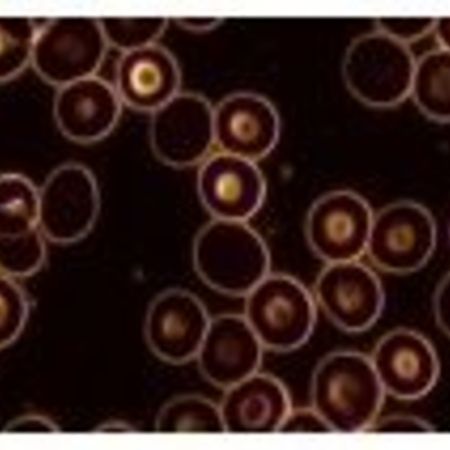
Dunkelfeldmikroskopie in der Detailaufnahme

Dunkelfeldmikroskopie - nach Pr. Enderlein
Ihr Blut spricht Bände.
Was ist die Dunkelfeldmikroskopie?
Dunkelfeld ist ein spezielles Beleuchtungsverfahren in der Lichtmikroskopie. Hierbei wird das Objekt von den Seiten her angestrahlt, der Hintergrund bleibt dunkel.
Der Vorteil dabei ist:
Feinste Objekte können hierdurch nicht von zu starkem Licht überblendet werden.
Zu sehen ist:
Während im konventionellen Blutbild die Anzahl der unterschiedlichen Blutkörperchen, Blutfettwerte und andere Parameter gemessen werden, wird in der Dunkelfelddiagnostik die Qualität aller Zellen im Blut beurteilt.
So ist es unter anderem möglich, die Aktivität von „Fresszellen“ zu beobachten. Mangelnde Abwehrbereitschaft des Immunsystems kann hier häufig erkannt werden. Auch Abweichungen in Größe und Form der Blutkörperchen, z.B. der roten, stellen eine der vielen krankhaften Veränderungen dar.
Und so läuft die Untersuchung ab:
Nach der Entnahme eines kleinen Bluttropfens aus der Fingerbeere wird dieser unter dem Dunkelfeldmikroskop betrachtet. Sie als Patient haben die Möglichkeit, die Bilder zu sehen während das Blutbild mit der Heilpraktikerin besprochen wird. Die daraus resultierende Therapie setzt sich unter anderem zusammen aus Homöopathie, Vitamintherapie, Pflanzentherapie und Enzymtherapie. (Für die Untersuchung sollten Sie 4-5 Stunden vorher nichts gegessen haben)

Training
Je ausgeglichener das Verhältnis zwischen tatsächlicher Belastung und optimaler Belastbarkeit ist, desto geringer sind die gesundheitlichen Probleme, die Ihnen Ihr Bewegungsapparat bereitet. Hier setzt die gerätegestützte Krankengymnastik im Rahmen eines ärztlich verordneten Rezepts gezielt an.
Mehr erfahrenPhysiotherapie
Jeder Physiopatient hat die Möglichkeit zu seiner verordneten Therapie eine betreute 4-wöchige Trainingseinheit dazu zu buchen, um einen größeren Therapieerfolg zu sichern. Therapiemaßnahmen werden durch einzigartige Hilfsmittel und Techniken unterstützt, die in der Region so gut wie einzigartig sind.
Mehr erfahrenKörperstatik
Vermessung der Körperstatik von Kopf bis Fuß nach einer Befundaufnahme.Die Korrektur: Sie beginnt an den Füßen. Aufgrund der vermessenen Statik werden unter die Fußsohlen ein bis drei Millimeter dünne Elemente aus Kunststoff, bzw. Kork gelegt, die die Körperstatik entscheidend verbessern können.
Mehr erfahrenNaturheilkunde
Nach der Entnahme eines kleinen Bluttropfens aus der Fingerbeere wird dieser unter dem Dunkelfeldmikroskop betrachtet. Sie als Patient haben die Möglichkeit, die Bilder zu sehen während das Blutbild mit der Heilpraktikerin besprochen wird.
Mehr erfahrenEntspannung
Diese Seite befindet sich noch im Aufbau! Um Sie auf gewohntem Niveau informieren zu können, werden wir noch ein wenig Zeit benötigen. Bitte schauen Sie daher bei einem späteren Besuch noch einmal auf dieser Seite vorbei.
Mehr erfahrenErnährung
Wenn Sie Körpergewicht verlieren möchten, müssen Sie wissen, wann Sie im Fettstoffwechsel sind. Nur dann wird Körperfett abgebaut. Aber nicht nur für das Gewichtsmanagement ist die Messung aufschlussreich, sondern auch für Ihre allgemeine Gesundheit. So kann ein Therapeut aufgrund der Messung neben Empfehlungen zu einem besseren Fettstoffwechsel auch Aussagen zu Ihrem Gesundheitsstatus machen.
Mehr erfahrenUnser Team stellt sich vor

